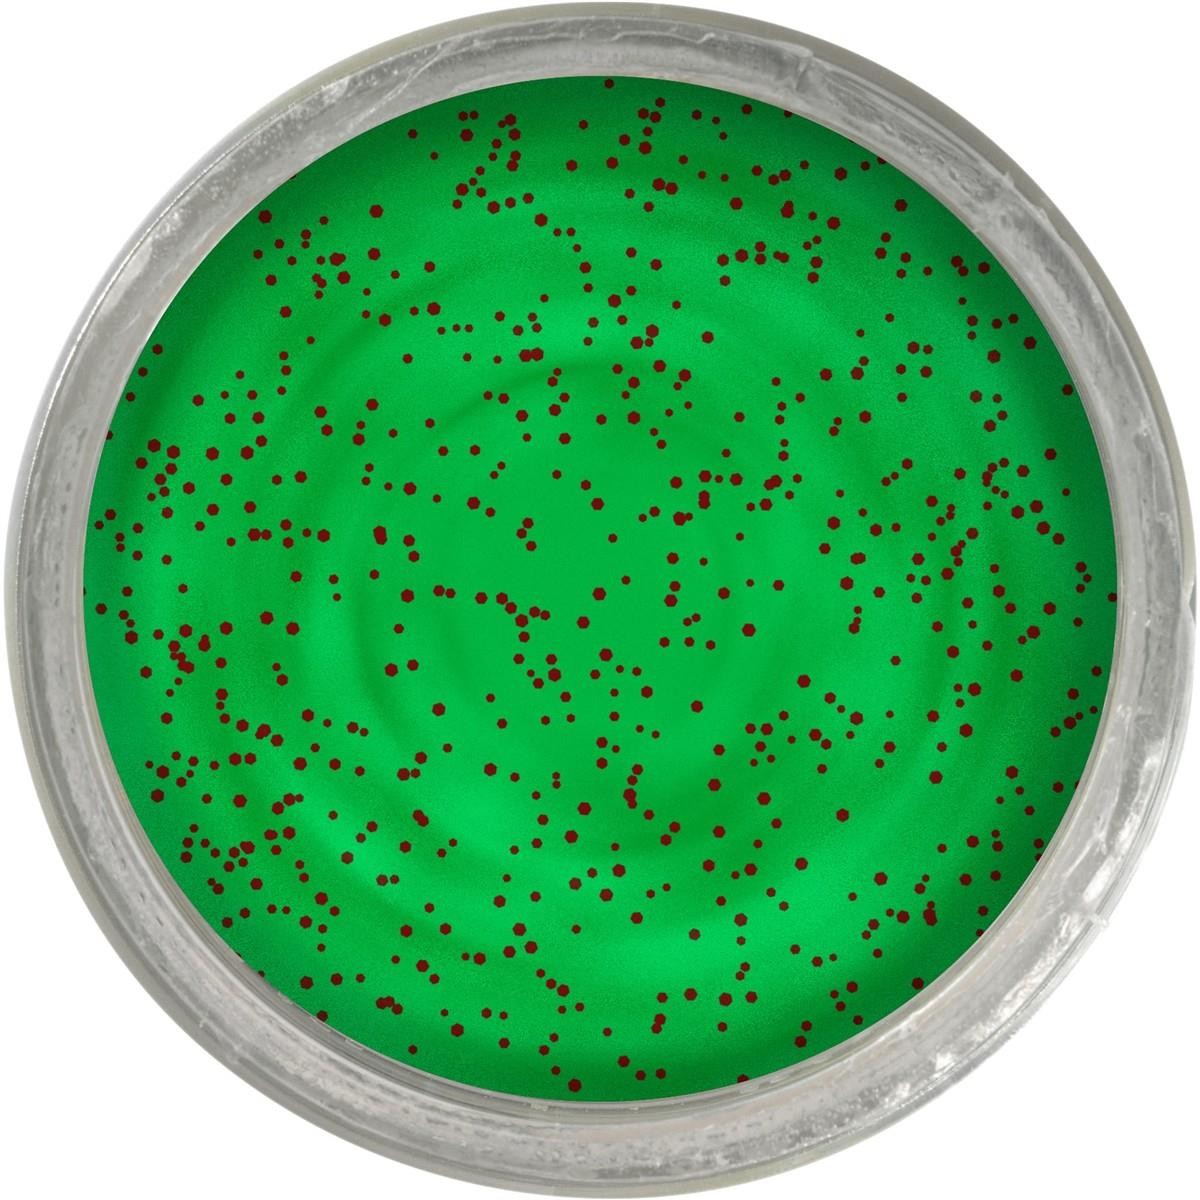
Наживка для форели Berkley Apple Jack, 50 г, Форелевая приманка для форели Schwimmend

Berkley
⭐ Купить товары Berkley на 23 мая по выгодным ценам от 100 до 57490 рублей. ✅ Выбирайте предложения с максимальной скидкой 73%. 🛍️ 6460 товаров в наличии от лучших интернет-магазинов Москвы и России. Сравните цены, фото и отзывы покупателей, чтобы сделать правильный выбор. Магазины-партнеры предоставляют удобные способы оплаты и быструю доставку. Найдите выгодные предложения и низкие цены на Берклеy в каталоге товаров Сashbe.
Популярные категории
Показать все
Популярные модели
Приманки и мормышки Berkley
Фантастика Berkley
Товары для собак Berkley

12 490₽
От
2 690₽
От

21 790₽
От

8 390₽
От

4 790₽
От

8 590₽
От

16 090₽
От

4 490₽
От

2 690₽
От

2 690₽
От

15 190₽
От

5 890₽
От

2 690₽
От

5 890₽
От

215₽
От Бетховен

2 690₽
От

5 890₽
От

5 390₽
От

2 690₽
От

3 190₽
От

15 790₽
От

22 490₽
От

2 690₽
От

2 690₽
От

12 890₽
От

9 290₽
От

28 790₽
От

261₽
От Бетховен

27 290₽
От

2 690₽
От

2 690₽
От

4 090₽
От

11 390₽
От

2 690₽
От

2 690₽
От

13 290₽
От

2 690₽
От

2 990₽
От

11 590₽
От

9 090₽
От

8 590₽
От

2 690₽
От

14 090₽
От

2 690₽
От
 -24%
-24%
876₽
1 152 ₽
От Старая ферма

16 990₽
От

2 690₽
От

5 890₽
От

9 290₽
От

2 690₽
От
- «
- ‹
- 1
- 2
- 3
- 4
- 5
- ›
Отзывы
Оставить отзыв о бренде
История становления легенды
Основанная в 1937 году, эта компания начала свой путь с производства рыболовных лесок, быстро завоевав доверие профессионалов и любителей. Инновационный подход и стремление к совершенству позволили ей занять лидирующие позиции в индустрии. Уже в середине XX века продукция бренда стала эталоном качества, а её разработки повлияли на развитие всего рыболовного рынка.
Ассортимент: от лесок до экипировки
Сегодня под этим именем выпускается широкий спектр товаров для рыбалки: удилища, катушки, приманки, аксессуары и специализированная экипировка. Особое внимание уделяется инновационным материалам – например, сверхпрочным полимерам для лесок или уникальным составам для приманок. Линейка продукции охватывает все виды ловли: от спиннинга до фидера, удовлетворяя запросы как новичков, так и опытных рыболовов.
Технологии, опережающие время
Berkley известен революционными разработками, такими как "жидкие" приманки с феромонами или "невидимые" лески с коэффициентом преломления света, близким к воде. Лаборатории компании постоянно работают над улучшением характеристик продукции, тестируя новые материалы в экстремальных условиях. Многие технологии, впервые применённые этим брендом, позже стали отраслевым стандартом.
Экологичность и устойчивое развитие
Производственные процессы организованы с минимальным воздействием на окружающую среду. Используются перерабатываемые материалы, сокращается углеродный след, а часть продукции создаётся из биоразлагаемых компонентов. Это сочетание высоких технологий и заботы о природе особенно ценится современными потребителями.
Признание профессионального сообщества
Продукция неоднократно получала награды на международных выставках и в специализированных рейтингах. Многие чемпионы мировых турниров по рыбной ловле выбирают снасти именно этого производителя, отмечая их надёжность и продуманность деталей. Тесное сотрудничество с профессиональными рыболовами позволяет непрерывно совершенствовать ассортимент.
Итог: неизменное качество
За десятилетия существования компания сохранила верность своим принципам: инновации, качество и внимание к потребностям рыбаков. Её продукция сочетает проверенные временем решения и передовые технологии, оставаясь выбором тех, кто ценит надёжность и эффективность. Это не просто бренд – это часть культуры современной рыбалки, где каждая деталь продумана до мелочей.

























































Новых отзывов пока нет, будь первым!